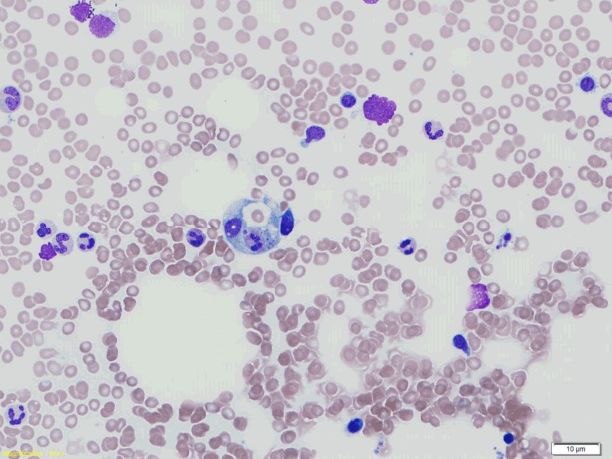
kjm-92-3-321f3.tif

여름에 발생한 혈구탐식림프조직구증을 동반한 중증쯔쯔가무시병 1예
- 안재성1, 노진희1, 김형래1, 정지원1, 조재철1, 임지훈2, 전재범1
Severe Scrub Typhus with Hemophagocytic Lymphohistiocytosis Occurring in Summer
- Jae-Sung Ahn1, Jin-Hee Noh1, Hyung-Rae Kim1, Jiwon Jung1, Jae-Cheol Jo1, Ji-Hun Lim2, Jae-Bum Jun1
- Received October 16, 2016; Revised February 3, 2017; Accepted February 3, 2017;
- Abstract
-
쯔쯔가무시병은 가을철에 호발하는 열성 질환이다. 저자들은 여름에 중증패혈증 양상을 보인 HLH 환자에서 쯔쯔가무시병을 진단하였으며, doxycycline으로 치료 후 호전을 보인 예를 경험하여 이를 보고하는 바이다.
- Abstract
-
In Korea, scrub typhus usually occurs in October and November. Hemophagocytic lymphohistiocytosis (HLH) is a distinct clinical entity characterized by a high fever, pancytopenia, hepatosplenomegaly, histiocyte proliferation, and hemophagocytosis. We encountered a summertime case of severe scrub typhus presenting as HLH. A 49-year-old female complained of abdominal pain and fever 3 days in duration. On hospital day 3 she was transferred to the intensive care unit because of clinical deterioration accompanied by severe sepsis. As an eschar was evident on the right shoulder, we commenced doxycycline. Her condition improved dramatically and she was discharged on day 14. Although the indirect immunofluorescence antibody test (IFA) for Orientia tsutsugamushi was negative on admission, a repeat IFA test was positive; the antibody titer was 1:5,120 on hospital day 10. Scrub typhus should be considered during differential diagnosis in a patient with severe sepsis in any season except the fall.
- 서 론
- 서 론
쯔쯔가무시병은 Orientia tsutsugamushi 감염에 의해 고열, 근육통, 두통 및 반점 구진성 발진 등을 나타내는 급성 열성질환이다. 쯔쯔가무시병은 연중 내내 발생이 가능하나, 90% 이상이 10월과 11월에 집중적으로 발생한다. 이는 우리나라에서 쯔쯔가무시병을 매개하는 털진드기의 유충인 chiggar의 밀집도가 가을에 높아지는 것과 관련이 있다[1]. 쯔쯔가무시병은 대부분 항생제로 치료가 잘 되지만 진단이 늦어질 경우 폐렴, 급성 신부전, 급성 호흡곤란증후군, 패혈성 쇼크, 뇌수막염이나 뇌염의 형태로 나타날 수 있으며, 이러한 합병증으로 인하여 사망할 수 있다[1].혈구탐식 림프조직구증(hemophagocytic lymphohistiocytosis, HLH)은 골수, 간 또는 림프절 등에 혈구탐식이 발생하면서 고열, 범혈구감소증, 간비장비대, 황달, 혈액응고장애 등을 특징으로 하는 질환이다[2]. HLH는 여러 감염, 자가면역 질환, 악성 종양 등과 연관이 있으며, 쯔쯔가무시병에 동반된 HLH는 국내외 문헌상 20예 이상이 보고되고 있다[3].저자들은 여름에 입원한 중증패혈증 양상을 보인 환자에서, HLH을 동반한 쯔쯔가무시병 1예를 경험하였기에 문헌고찰과 함께 보고하는 바이다.
- 증 례
- 증 례
2015년 8월 기저 질환이 없는 49세 여자 환자가 1일 전 발생한 복통을 주소로 내원하였다. 환자는 농촌에 거주하는 자로 내원 10일 전에 오른쪽 어깨에 벌레 물린 것 같은 느낌을 호소하였다. 내원 3일 전부터 열감 및 오한이 있었으며, 내원 1일 전부터는 우상복부의 통증이 생겨 본원으로 내원하였다.환자는 급성 병색이었으며, 의식은 명료하였다. 식욕 저하 및 하루 한두 차례 정도의 묽은 변을 보았다. 복통의 위치는 상복부 및 우상복부의 모호한 양상의 통증이었다. 통증은 한번 시작되면 30분 이내에 소실되었으며, 하루에 4, 5차례 정도 증상이 있었다. 압통은 있었으나 반발압통은 없었다. 내원시 혈압은 114/77 mmHg, 맥박수 100회/분, 호흡수 20회/분, 체온 38.7도였으며, 이학적 검사에서 발진은 보이지 않았으며, 림프절도 만져지지 않았다.일반혈액 검사에서 총 백혈구 9,780/mm3 (호중구 76%, 띠중성구 20%), 혈색소 13.0 g/dL, 혈소판 60,000/mm3로 측정되었다. 혈액생화학적 검사에서는 아스파르테이트아미노 전이효소 398 IU/L, 알라닌아미노 전이효소 260 IU/L, 알칼리인산 분해효소 379 IU/L, 감마-글루타밀트랜스펩티다제 449 IU/L, 결합빌리루빈 1.9 mg/dL, 비결합빌리루빈 1.6 mg/dL, C-반응단백 11.91 mg/dL 등의 이상 소견이 관찰되었다. A형, B형, C형 바이러스성 간염에 대한 혈청학적 검사는 음성이었다.복부 및 흉부 전산화단층촬영에서 비장비대 소견을 보였으며, 담낭의 장막하층의 부종 소견이 관찰되었다. 급성 췌담도계 감염을 의심할 만한 소견은 관찰되지 않았지만, 발열과 복통을 설명할 만한 다른 뚜렷한 원인이 없어서, ceftizoxime (2 g IV q 8 hours)와 metronidazole (500 mg IV q 8 hours)을 투여하면서 추가적인 자기공명 쓸개이자조영술 혹은 내시경 역행 췌담관조영술 등의 검사를 계획하였다.제2병일에 복통, 발열 지속되었으며, 저산소증 및 의식변화 등 중증패혈증의 양상 나타나기 시작하였다. D-이합체 25.98 ug/mL, 항트롬빈 III 71%, 피브린분해산물 98.4 ug/mL, 혈청페리틴 11,000 ng/mL, 젖산탈수소효소 868 IU/L로 측정되었다. 경험적 항생제를 meropenem (1g IV q 8 hours), vancomycin (1 g IV q 12 hours)으로 변경하였다. 항생제 변경 후에도 발열 지속되었으며, 제3병일에 호흡곤란이 발생하면서, 흉부 X-ray 상에서 양쪽 폐야로 전반적인 음영증가가 관찰되었다(Fig. 1). 분당 호흡수 24회/분, 경피적 산소포화도 89%로 산소 2 L 적용 후 시행한 동맥혈 검사에서 산도 7.51, 이산화탄소 분압 22.7 mmHg, 산소 분압 53.8 mmHg, 중탄산염 17.8 mEq, 산소포화도 90%, 젖산 1.55 mmol/L로 중환자실로 전동하였다. 제4병일에 환자는 호흡곤란이 심해지면서 흉부 X-ray 상에서 양쪽 폐야의 음영증가가 더 심해졌다. 입원 당시 시행한 O. tsutsugamushi, 발진열리케치아(Rickettsia typhi), 한탄바이러스(Hantaan virus)에 대한 간접 면역형광검사법항체(indirect immunofluorescence antibody test, IFA)는 모두 음성이었다. 거대세포바이러스(cytomegalovirus), 엡스타인-바바이러스(Ebstein-Barr virus, EBV) 중합효소연쇄반응, 형광항핵항체 검사(fluorescent anti-nuclear antibody)도 음성이었다. 제4병일째부터 항체는 음성이었으나, 오른쪽 어깨의 병변은 가피(Fig. 2)로 생각되었으며, scrub typhus를 고려하여 doxycycline을 추가하였다. 제5병일째는 호흡곤란 및 발열 다소 호전 추세였다. 심장 초음파 검사 상에서는 좌심실 구혈률 63%, 소량의 심낭삼출액이 관찰되었다. 골수 검사에서 조직구의 증가 및 이들에 의한 과립구, 적혈구, 혈소판 등이 탐식되고 있는 소견이 관찰되었다(Fig. 3). 제6병일부터 발열 및 호흡곤란이 지속적으로 호전 추세였으며, 제7병일은 다시 일반병실로 전동되었다. 제9병일에는 흉부 X-ray 상에서 폐야의 음영증가도 호전되었고, 산소요구량이 감소하여 산소를 중단하였다. 제10병일에는 발열이 있을 당시 시행한 혈액 배양 검사 상에서 모두 음성이었으므로, meropenem, vancomycin을 ceftriaxone으로 변경하였으며, doxycycline은 그대로 유지하였다. O. tsutsugamushi에 대한 간접 면역형광검사법항체(IFA)를 다시 시행하였으며, 항체가 1:5,120으로 쯔쯔가무시병으로 진단되었으며 제14병일에 퇴원하였다.
- 고 찰
- 고 찰
쯔쯔가무시병은 주로 가을철에 호발하는 급성 열성 질환이다. 9월부터 증가하기 시작하여, 10월에 절정을 이루며, 11월부터 감소하기 시작한다[1]. 여름에 발생하는 쯔쯔가무시병은 드물며, 질병관리본부 자료에 따르면 2012-2014년까지 여름에 발생한 쯔쯔가무시병은 전체(27,099예)에서 1% (6, 7, 8월, 282예) 정도에 불과하다. 보고된 예들에 대해서는 정확한 기술이 없어, 항체만 양성인지 실제 환자인지는 분명하지 않다[4]. 쯔쯔가무시병이 주로 가을에 호발하는 이유는 국내에서 쯔쯔가무시병을 전파한다고 알려진 털진드기인 L. pallidum, L. palpale, L. scutellare의 유충 수가 10-11월에 증가하는 것과 관련이 있을 것으로 생각된다. 털진드기는 알, 유충, 자충, 성충의 4단계의 생활사를 거치는데 1년 내내 산란을 하는 열대지방에서와는 달리 우리나라와 같은 고위도 지방에서는 가을과 겨울에는 산란이 중지되는 반면 여름철이 성충이 산란이 집중되는 시기로 추정된다[1].쯔쯔가무시병은 간접 면역형광검사법이 진단의 표준방법으로 사용된다. 급성기와 회복기 혈청에서 항체가가 4배 이상 상승과 단일 혈청 검사상 IgM 항체가 1:16 이상이거나 IgG 항체가 1:256 이상일 때 쯔쯔가무시병으로 진단할 수 있다. 본 증례에서는 입원 당시 시행한 간접 면역형광 검사 상에서 음성이었으며, 제10병일에 시행한 검사 상에서 1:5,120으로 양성으로 나와 확진된 경우이다[1]. Lee 등[5]에 의하면, 쯔쯔가무시병이 의심되어 혈청학적 검사 및 약물 투여를 시행한 환자를 대상으로 한 연구에서 간접 면역형광법으로는 급성기 85%만이 양성으로 나왔으며, 추후에 다시 시행한 검사에는 100% 양성으로 쯔쯔가무시병을 진단하였다. 본 증례도 내원 당시에는 간접 면역형광법으로 시행한 검사 상에서 음성이었으나 추후에 양성으로 나와 쯔쯔가무시병을 진단할 수 있었다.발진과 가피(eschar)는 쯔쯔가무시병에서 특징적인 증상이다. 발진은 보통 발병 3-7일에 몸통에서 시작하여 상, 하지로 퍼지는 소양감이 동반되지 않는 홍반성 구진성 양상으로 나타나게 되며 발생 1-2주에 사라진다. 전형적인 가피는 중앙의 검정색 딱지 주위라 약간 융기된 붉은색의 홍반으로 관찰된다. 우리나라에는 가피는 충청도 이남 지역의 경우 80-83% 정도로 보고되고 있으나 강원도 환자를 대상으로 한 연구에서는 46%를 보고한 바 있다[6]. 본 증례는 비유행시기에 내원한 환자로, 가피는 있었으나, 발진이 없었고, 내원시 시행한 간접 면역형광법에서 음성이어서, 진단에 어려움이 있었다.환자는 내원 제3병일째 중증패혈증 양상을 보이며 중환자실로 전동하였으며, 기계호흡까지 고려하였으나 doxycycline을 사용 후 1-2일만에 급격한 호전을 보였다. 원인 모를 발열, 중증패혈증, 범혈구감소증으로 골수검사를 시행하였으며, 검사상 혈구탐식이 관찰되었다. HLH는 1) 일주일 이상 지속되는 고열(> 38.5℃), 2) 간비장비대, 3) 혈구감소증(혈색소 < 9.0 g/dL, 혈소판 < 100,000/mm3, 절대호중구 < 1,000/mm3 중 2가지 이상), 4) 고중성지방혈증 또는 저섬유소원증, 5) 악성 질환의 증거가 없이 골수, 비장, 혹은 림프절에 혈구탐식증이 관찰될 때, 6) natural killer 세포활성의 감소, 7) 고페리틴혈증(> 500 ng/mL), 8) soluble CD25 (soluble interleukin-2-receptor) > 2,400 U/mL의 8가지 소견 중 5가지 이상을 만족할 때 진단할 수 있다[7]. 본 증례의 경우에는 6)과 8)을 제외한 6가지 소견을 만족시켜 HLH로 진단할 수 있었다.중증패혈증과 HLH는 비슷한 임상 양상을 보일 수 있는데 ferritin level이 HLH를 감별하는데 도움을 줄 수 있다. Palazzi 등[8]에 의하면, HLH 환자의 95%에서 ferritin이 4,000 ng/mL 이상의 수치를 보였으며 58%에서는 10,000 ng/mL 이상의 높은 수치를 보였다. 또한 10,000 ng/mL 이상의 ferritin level은 HLH를 진단하는데 90%의 민감도와 96%의 특이도를 보인다는 연구도 있었다[9]. 본 증례에서도 환자는 매우 높은 ferritin 수치(11,000 ng/mL)를 보였으며, 이 점이 HLH를 감별하는데 도움이 되었다.감염과 동반된 HLH의 경우에는 대부분 보존적 치료와 기저 질환의 치료로 호전을 보이는 것으로 되어있으며, EBV의 경우에는 예후가 좋지 않은 것으로 되어 있다[2]. 쯔쯔가무시병에 동반된 HLH는 전 세계적으로 21예 보고되었다. 그중 11예에서 doxycycline 단독치료로 호전되었으며, 3예는 minocycline, 4예는 doxycycline에 면역 억제 치료(etoposide 2예, HLH-2004 protocol 2예)를 함께 시행하였으며, 2예는 doxycycline에 steroid만 사용하였으며 모두 호전되었다. 1예에서만 항생제 및 보존적 치료를 시행하다 사망하였다[3]. 본 증례에서는 골수 검사 결과 확인 시점에 증상이 호전되고 있어서, 추가적인 면역 억제 치료는 시행하지 않았다. 상기 21예에서 대부분 계절에 대한 언급은 없었으며 문헌고찰상 여름에 HLH로 발현한 case에 대한 증례는 없었다. 감염에 의한 이차적인 HLH의 경우 조기에 기저 감염에 대한 적절한 치료를 하는 것이 중요하다. 본 증례는 드물지만 여름에도 쯔쯔가무시병이 있을 수 있고 중증 형태인 HLH로 나타날 수 있기 때문에 적절한 이학적 검사로 발진과 가피 등을 확인하는 것이 중요하다는 교훈점이 있다고 생각한다.쯔쯔가무시병은 우리나라에서 가을철에 흔히 볼 수 있는 질환이며, 중증 경과를 보일 수 있는 질환이다. 본 증례에서는 여름이라는 계절특성 및 간접 면역형광법 검사상 음성으로 진단에 어려움이 있었다. 중증 경과를 보였으나, 가피를 고려하여 doxycycline이 투여된 후 빠른 회복을 보였다. 원인 모르는 중증패혈증, HLH 환자에서 가을철이 아니더라도 쯔쯔가무시병을 감별 진단으로 고려할 수 있겠으며, doxycycline의 선택적 사용도 고려해 볼 수 있을 것으로 생각된다.
Figure 1.
A chest radiograph taken on hospital day 3 (B) revealed extensions of the ill-defined consolidations and increased interstitial marks on both lungs compared to what was apparent on the chest radiograph taken at admission (A).

Figure 3.
A bone marrow aspiration specimen exhibits hemophagocytosis of neutrophils and platelets (Wright-Giemsa stain, ×1,000).
- References
- References
REFERENCES
1. Kim DM. Clinical features and diagnosis of scrub typhus. Infect Chemother 2009;41:315–322.
[Article]2. Janka G, Imashuku S, Elinder G, Schneider M. Infection- and malignancy-associated hemophagocytic syndromes. Secondary hemophagocytic lymphohistiocytosis. Hematol Oncol Clin North Am 1998;12:435–444.
[Article] [PubMed]3. Basheer A, Padhi S, Boopathy V, et al. Hemophagocytic lymphohistiocytosis: an unusual complication of orientia tsutsugamushi disease (scrub typhus). Mediterr J Hematol Infect Dis 2015;7:e2015008.
[Article]4. Korea Center for Disease Control and Prevention. Infectious Disease Surveillance Yearbook, 2014 [Internet]. Cheongju (KR): Korea Center for Disease Control and Prevention, c2015. [cited 2015 Jul 1]. Available from: http://www.cdc.go.kr/CDC/info/CdcKrInfo0302.jsp?menuIds=HOME001-MNU1132-MNU1138-MNU0038&fid=32&q_type=&q_value=&cid=63970&pageNum=.5. Lee CS, Kwon KS, Nha SE, Lee HB. Comparison of passive hemagglutination and indirect immunofluorescence assay for the diagnosis of scrub typhus. Infect Chemother 2008;40:46–48.
[Article]6. Choi DS, Lee KH, Park JH, et al. The study of 24 cases of Tsutsugamushi disease in Gang-Won-Do in the autumn of 1988. Korean J Med 1989;37:362–369.7. Henter JI, Horne A, Aricó M, et al. HLH-2004: diagnostic and therapeutic guidelines for hemophagocytic lymphohistiocytosis. Pediatr Blood Cancer 2007;48:124–131.
[Article] [PubMed]

